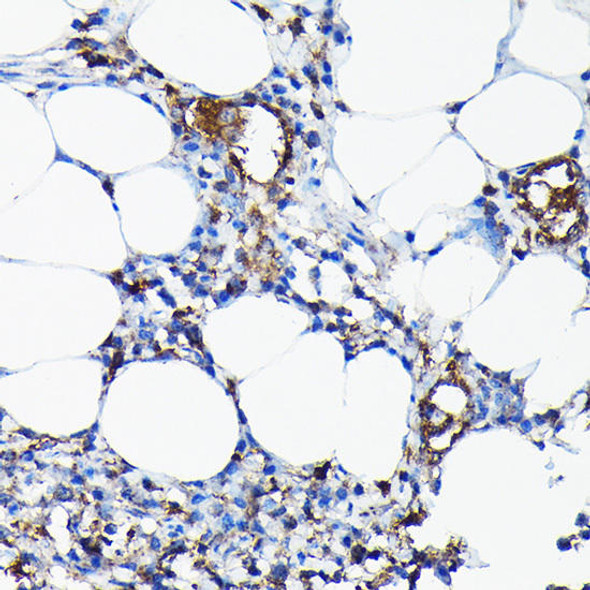
CYP1A1 Rabbit Polyclonal Antibody (CAB2159)

Description
CYP1A1/CYP1A2 Antibody (PACO00661)
The CYP1A1/CYP1A2 Antibody (PACO00661) is a highly specific tool for researchers studying the cytochrome P450 enzymes CYP1A1 and CYP1A2. These enzymes play essential roles in the metabolism of various endogenous and exogenous compounds, making them key players in drug metabolism, detoxification processes, and the activation of carcinogens.Raised in rabbits, this polyclonal antibody is optimized for use in Western blot applications and has been extensively validated for its specificity and sensitivity in detecting CYP1A1 and CYP1A2 in human samples. Its high reactivity and ability to bind to these enzymes make it an invaluable resource for studying the expression levels and distribution of CYP1A1 and CYP1A2 in different tissues and cell types.
Researchers in the fields of pharmacology, toxicology, and environmental health will benefit from using this antibody to gain insights into the mechanisms of drug metabolism, chemical detoxification, and the role of cytochrome P450 enzymes in various disease states. By understanding the activity and regulation of CYP1A1 and CYP1A2, researchers can develop targeted therapies and interventions for conditions related to disrupted drug metabolism and xenobiotic metabolism.
| Antibody Name: | CYP1A1/CYP1A2 Antibody |
| Antibody SKU: | PACO00661 |
| Size: | 50ug |
| Host Species: | Rabbit |
| Tested Applications: | ELISA, WB, IHC, IF |
| Recommended Dilutions: | WB:1:500-1:2000, IHC:1:100-1:300, IF:1:200-1:1000 |
| Species Reactivity: | Human, Mouse, Rat, Monkey |
| Immunogen: | synthesized peptide derived from the Internal region of human CYP1A1/2. |
| Form: | Liquid |
| Storage Buffer: | Liquid in PBS containing 50% glycerol, 0.5% BSA and 0.02% sodium azide. |
| Purification Method: | The antibody was affinity-purified from rabbit antiserum by affinity-chromatography using epitope-specific immunogen. |
| Clonality: | Polyclonal |
| Isotype: | IgG |
| Conjugate: | Non-conjugated |
| Synonyms: | CYP1A1; Cytochrome P450 1A1; CYPIA1; Cytochrome P450 form 6; Cytochrome P450-C; Cytochrome P450-P1; CYP1A2; Cytochrome P450 1A2; CYPIA2; Cytochrome P(3)450; Cytochrome P450 4; Cytochrome P450-P3 |
| UniProt Protein Function: | CYP1A1: Cytochromes P450 are a group of heme-thiolate monooxygenases. In liver microsomes, this enzyme is involved in an NADPH-dependent electron transport pathway. It oxidizes a variety of structurally unrelated compounds, including steroids, fatty acids, and xenobiotics. Belongs to the cytochrome P450 family. |
| UniProt Protein Details: | Protein type:Cofactor and Vitamin Metabolism - retinol; Amino Acid Metabolism - tryptophan; Oxidoreductase; EC 1.14.14.1; Xenobiotic Metabolism - metabolism by cytochrome P450 Chromosomal Location of Human Ortholog: 15q24.1 Cellular Component: endoplasmic reticulum membrane; mitochondrion Molecular Function:oxidoreductase activity, acting on diphenols and related substances as donors; flavonoid 3'-monooxygenase activity; enzyme binding; iron ion binding; heme binding; oxidoreductase activity; steroid hydroxylase activity; oxygen binding; demethylase activity Biological Process: coumarin metabolic process; response to nematode; response to arsenic; response to lipopolysaccharide; cellular lipid metabolic process; response to vitamin A; response to antibiotic; embryonic development ending in birth or egg hatching; flavonoid metabolic process; porphyrin metabolic process; response to wounding; arachidonic acid metabolic process; drug metabolic process; aging; response to food; response to drug; insecticide metabolic process; camera-type eye development; response to iron(III) ion; response to virus; epoxygenase P450 pathway; response to herbicide; dibenzo-p-dioxin catabolic process; vitamin D metabolic process; cell proliferation; response to hyperoxia; gut development; xenobiotic metabolic process; maternal process involved in parturition; response to hypoxia; 9-cis-retinoic acid biosynthetic process; amine metabolic process; hydrogen peroxide biosynthetic process |
| NCBI Summary: | This gene, CYP1A1, encodes a member of the cytochrome P450 superfamily of enzymes. The cytochrome P450 proteins are monooxygenases which catalyze many reactions involved in drug metabolism and synthesis of cholesterol, steroids and other lipids. This protein localizes to the endoplasmic reticulum and its expression is induced by some polycyclic aromatic hydrocarbons (PAHs), some of which are found in cigarette smoke. The enzyme's endogenous substrate is unknown; however, it is able to metabolize some PAHs to carcinogenic intermediates. The gene has been associated with lung cancer risk. A related family member, CYP1A2, is located approximately 25 kb away from CYP1A1 on chromosome 15. [provided by RefSeq, Jul 2008] |
| UniProt Code: | P04798 |
| NCBI GenInfo Identifier: | 117139 |
| NCBI Gene ID: | 1543 |
| NCBI Accession: | P04798.1 |
| UniProt Secondary Accession: | P04798,Q53G18, A4F3V9, A4F3W0, |
| UniProt Related Accession: | P04798 |
| Molecular Weight: | 58kDa |
| NCBI Full Name: | Cytochrome P450 1A1 |
| NCBI Synonym Full Names: | cytochrome P450, family 1, subfamily A, polypeptide 1 |
| NCBI Official Symbol: | CYP1A1 |
| NCBI Official Synonym Symbols: | AHH; AHRR; CP11; CYP1; P1-450; P450-C; P450DX |
| NCBI Protein Information: | cytochrome P450 1A1; CYPIA1; cytochrome P450-C; cytochrome P450-P1; cytochrome P450 form 6; xenobiotic monooxygenase; aryl hydrocarbon hydroxylase; flavoprotein-linked monooxygenase; cytochrome P1-450, dioxin-inducible; cytochrome P450, subfamily I (aromatic compound-inducible), polypeptide 1 |
| UniProt Protein Name: | Cytochrome P450 1A1 |
| UniProt Synonym Protein Names: | CYPIA1; Cytochrome P450 form 6; Cytochrome P450-C; Cytochrome P450-P1 |
| Protein Family: | Cytochrome |
| UniProt Gene Name: | CYP1A1 |
| UniProt Entry Name: | CP1A1_HUMAN |